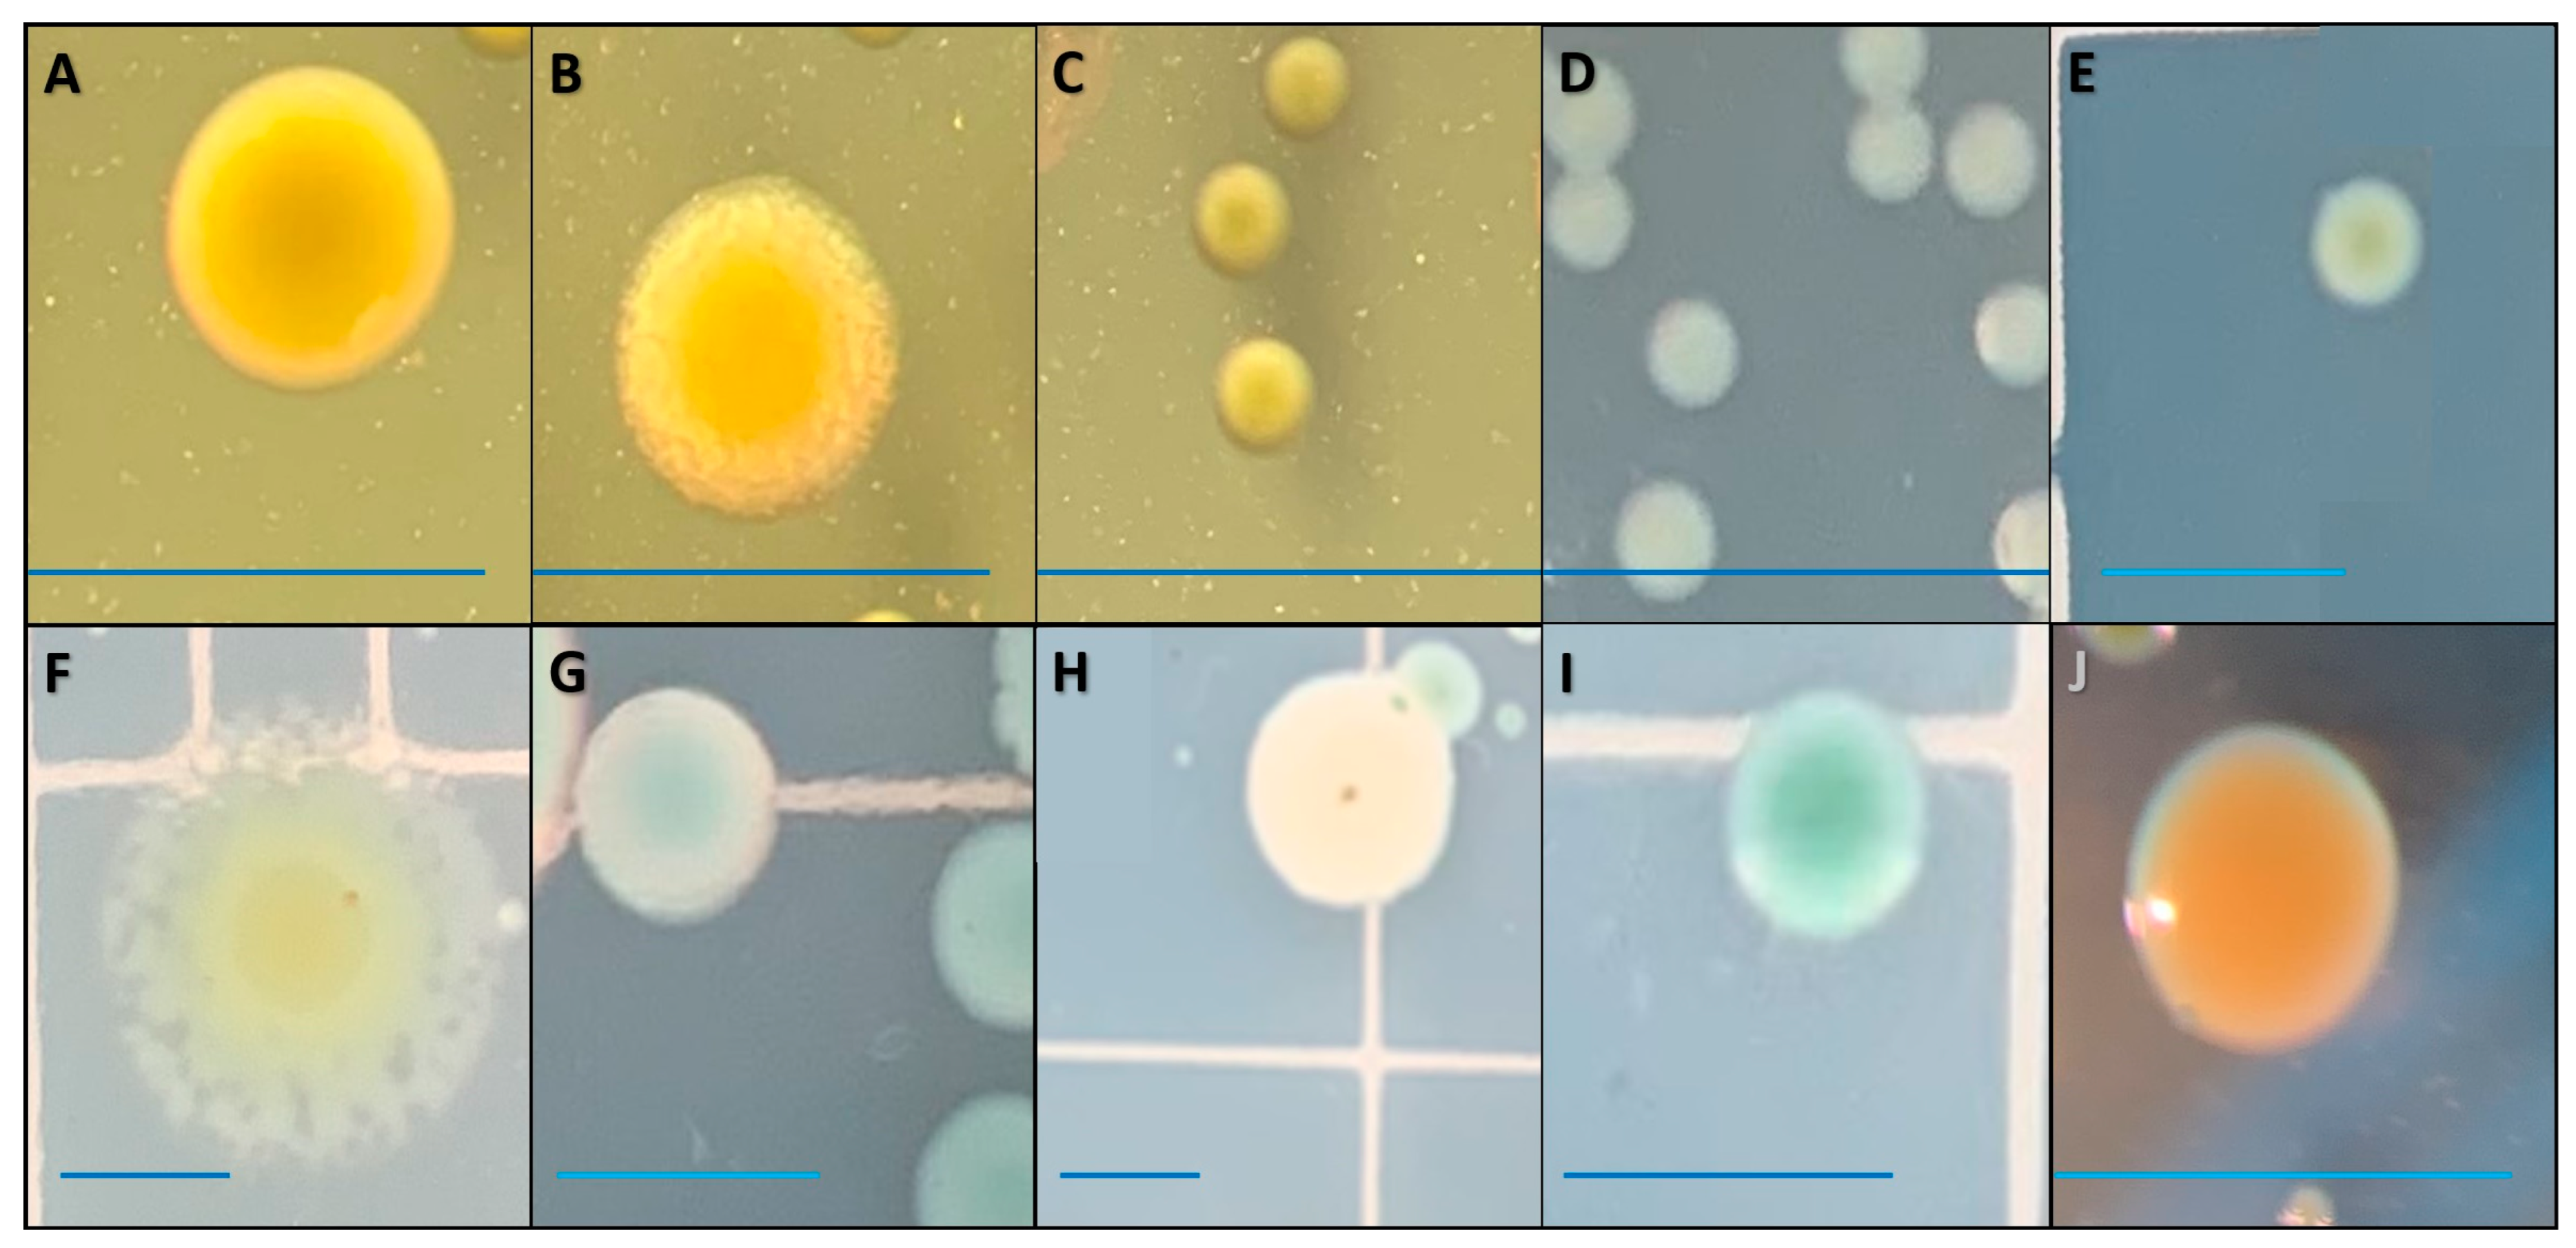
Pathogens 12 00871 g004

Investigating the Ability of Edwardsiella ictaluri and Flavobacterium covae to Persist within Commercial Catfish Pond Sediments under Laboratory Conditions
Abstract
1. Introduction
1.1. Edwardsiella ictaluri
1.2. Flavobacterium covae
2. Materials and Methods
2.1. Previous Study
2.2. Experimental Design and System Preparation
2.3. Bacterial Culture and Trial Preparation
2.4. Sampling and Bacterial Enumeration
2.5. DNA Extraction and PCR Confirmation
2.6. Sediment, Water, and Statistical Analysis
3. Results
3.1. Edwardsiella ictaluri Persistence Trail
3.1.1. Sampling and Bacterial Enumeration
3.1.2. Bacterial Isolate Genetic Confirmation
3.1.3. Sediment and Water Analysis
3.2. Flavobacterium covae Persistence Trial
4. Discussion
5. Conclusions
Author Contributions
Funding
Institutional Review Board Statement
Informed Consent Statement
Data Availability Statement
Acknowledgments
Conflicts of Interest
References
- Engle, C.R.; Hanson, T.; Kumar, G. Economic history of US catfish farming: Lessons for growth and development of aquaculture. Aquac. Econ. Manag. 2022, 26, 1–35. [Google Scholar] [CrossRef]
- Abdelrahman, H.A.; Hemstreet, W.G.; Roy, L.A.; Hanson, T.R.; Beck, B.H.; Kelly, A.M. Epidemiology and economic impact of disease-related losses on commercial catfish farms: A seven-year case study from Alabama, USA. Aquaculture 2023, 566, 739206. [Google Scholar] [CrossRef]
- Hawke, J.P.; Mcwhorter, A.C.; Steigerwalt, A.G.; Brenner, D.J. Edwardsiella ictaluri sp. nov., the causative agent of enteric septicemia of catfish. Int. J. Syst. Evol. Microbiol. 1981, 31, 396–400. [Google Scholar] [CrossRef]
- LaFrentz, B.R.; Králová, S.; Burbick, C.R.; Alexander, T.L.; Phillips, C.W.; Griffin, M.J.; Waldbieser, G.C.; García, J.C.; de Alexandre Sebastião, F.; Soto, E.; et al. The fish pathogen Flavobacterium columnare represents four distinct species: Flavobacterium columnare, Flavobacterium covae sp. nov., Flavobacterium davisii sp. nov. and Flavobacterium oreochromis sp. nov., and emended description of Flavobacterium columnare. Syst. Appl. Microbiol. 2022, 45, 126293. [Google Scholar] [CrossRef]
- Hawke, J.P. A bacterium associated with disease of pond cultured channel catfish, Ictalurus punctatus. J. Fish. Res. Board Can. 1979, 36, 1508–1512. [Google Scholar] [CrossRef]
- Collins, L.A.; Thune, R.L. Development of a defined minimal medium for the growth of Edwardsiella ictaluri. Appl. Environ. Microbiol. 1996, 62, 848–852. [Google Scholar] [CrossRef]
- Shotts, E.B.; Blazer, V.S.; Waltman, W.D. Pathogenesis of experimental Edwardsiella ictaluri infections in Channel Catfish (Ictalurus punctatus). Can. J. Fish. Aquat. Sci. 1986, 43, 36–42. [Google Scholar] [CrossRef]
- Janda, J.M.; Abbott, S.L.; Kroske-Bystrom, S.; Cheung, W.K.; Powers, C.; Kokka, R.P.; Tamura, K. Pathogenic properties of Edwardsiella species. J. Clin. Microbiol. 1991, 29, 1997–2001. [Google Scholar] [CrossRef] [PubMed]
- Thune, R.L.; Hawke, J.P.; Fernandez, D.H.; Lawrence, M.L.; Moore, M.M. Immunization with bacterial antigens: Edwardsiellosis. Dev. Biol. Stand. 1997, 90, 125–134. [Google Scholar]
- Hanson, T.R.; Shaik, S.; Coble, K.H.; Edwards, S.; Miller, J.C. Identifying risk factors affecting weather-and disease-related losses in the US farm-raised catfish industry. Agric. Resour. Econ. Rev. 2008, 37, 27–40. [Google Scholar] [CrossRef]
- Peterman, M.A.; Posadas, B.C. Direct economic impact of fish diseases on the east Mississippi catfish industry. N. Am. J. Aquac. 2019, 81, 222–229. [Google Scholar] [CrossRef]
- Griffin, M.J.; Greenway, T.E.; Byars, T.S.; Ware, C.; Aarattuthodiyil, S.; Kumar, G.; Wise, D.J. Cross-protective potential of a live-attenuated Edwardsiella ictaluri vaccine against Edwardsiella piscicida in channel (Ictalurus punctatus) and channel × blue (Ictalurus furcatus) hybrid catfish. J. World Aquac. Soc. 2020, 51, 740–749. [Google Scholar] [CrossRef]
- Wise, A.L.; LaFrentz, B.R.; Kelly, A.M.; Khoo, L.H.; Xu, T.; Liles, M.R.; Bruce, T.J. A review of bacterial co-infections in farmed catfish: Components, diagnostics, and treatment directions. Animals 2021, 11, 3240. [Google Scholar] [CrossRef]
- Wise, D.J.; Greenway, T.E.; Byars, T.S.; Griffin, M.J.; Khoo, L.H. Oral vaccination of channel catfish against enteric septicemia of catfish using a live attenuated Edwardsiella ictaluri isolate. J. Aquat. Anim. Health 2015, 27, 135–143. [Google Scholar] [CrossRef]
- Wise, D.J.; Greenway, T.E.; Byars, T.S.; Kumar, G.; Griffin, M.J.; Khoo, L.H.; Chesser, G.; Lowe, J. Validation of Edwardsiella ictaluri oral vaccination platform in experimental pond trials. J. World Aquac. Soc. 2020, 51, 346–363. [Google Scholar] [CrossRef]
- Hegde, S.; Kumar, G.; Engle, C.; Hanson, T.; Roy, L.A.; Cheatham, M.; Avery, J.; Aarattuthodiyil, S.; van Senten, J.; Johnson, J.; et al. Technological progress in the US catfish industry. J. World Aquac. Soc. 2022, 53, 367–383. [Google Scholar] [CrossRef]
- Wolters, W.R.; Johnson, M.R. Enteric septicemia resistance in blue catfish and three channel catfish strains. J. Aquat. Anim Health 1994, 6, 329–334. [Google Scholar] [CrossRef]
- Wolters, W.R.; Wise, D.J.; Klesius, P.H. Survival and antibody response of channel catfish, blue catfish, and channel catfish female × blue catfish male hybrids after exposure to Edwardsiella ictaluri. J. Aquat. Anim. Health 1996, 8, 249–254. [Google Scholar] [CrossRef]
- Bosworth, B.G.; Wolters, W.R.; Wise, D.J.; Klesius, P.H. Genetic effects for response to live Edwardsiella ictaluri, killed E. ictaluri, and stress in juveniles from all crosses among USDA 103, USDA 102, and Norris channel catfish Ictalurus punctatus strains. J. World Aquac. Soc. 2004, 35, 78–86. [Google Scholar] [CrossRef]
- Reichley, S.R.; Ware, C.; Khoo, L.H.; Greenway, T.E.; Wise, D.J.; Bosworth, B.G.; Lawrence, M.L.; Griffin, M.J. Comparative susceptibility of channel catfish, Ictalurus punctatus; blue catfish, Ictalurus furcatus; and channel (♀) × blue (♂) hybrid catfish to Edwardsiella piscicida, Edwardsiella tarda, and Edwardsiella anguillarum. J. World Aquac. Soc. 2018, 49, 197–204. [Google Scholar] [CrossRef]
- Evans, J.J.; Klesius, P.H.; Plumb, J.A.; Shoemaker, C.A. Edwardsiella septicaemias. In Fish Diseases and Disorders; Viral, Bacterial and Fungal Infections; Woo, P.T.K., Bruno, D.W., Eds.; CABI: Wallingford, UK, 2011; Volume 3, pp. 512–569. ISBN 978-1-84593-580-1. [Google Scholar]
- Abdelhamed, H.; Lawrence, M.L.; Karsi, A. The role of TonB gene in Edwardsiella ictaluri virulence. Front. Physiol. 2017, 8, 1066. [Google Scholar] [CrossRef] [PubMed]
- Kumar, G.; Byars, T.S.; Greenway, T.E.; Aarattuthodiyil, S.; Khoo, L.H.; Griffin, M.J.; Wise, D.J. Economic assessment of commercial-scale Edwardsiella ictaluri vaccine trials in US catfish industry. Aquac. Econ. Manag. 2019, 23, 254–275. [Google Scholar] [CrossRef]
- Booth, N.J.; Elkamel, A.; Thune, R.L. Intracellular replication of Edwardsiella ictaluri in channel catfish macrophages. J. Aquat. Anin. Health 2006, 18, 101–108. [Google Scholar] [CrossRef]
- Mqolomba, T.N.; Plumb, J.A. Longevity of Edwardsiella ictaluri in the organs of experimentally infected channel catfish, Ictalurus punctatus. Aquaculture 1992, 101, 1–6. [Google Scholar] [CrossRef]
- Klesius, P. Transmission of Edwardsiella ictaluri from infected, dead to noninfected channel catfish. J. Aquat. Anim. Health 1994, 6, 180–182. [Google Scholar] [CrossRef]
- Shotts, E.B.; Plumb, J.A. 1.2.6 Enteric septicemia. In FHS Blue Book: Diagnostic Procedures for Finfish and Shellfish Pathogens; AFS-FHS (American Fisheries Society-Fish Health Section): Bethesda, MD, USA, 2014. [Google Scholar]
- Klesius, P.H. Carrier state of channel catfish infected with Edwardsiella ictaluri. J. Aquat. Anim. Health 1992, 4, 227–230. [Google Scholar] [CrossRef]
- USDA (US. Department of Agriculture); NAHMS (National Animal Health Monitoring Sercive). Catfish 2010, Part II: Health and Production Practices for Foodsize Catfish in the United States, 2009; USDA, Animal and Plant Health Inspection Service, Veterinary Services, Center for Epidemiology and Animal Health: Fort Collins, CO, USA, 2010. [Google Scholar]
- Ran, C.; Carrias, A.; Williams, M.A.; Capps, N.; Dan, B.C.; Newton, J.C.; Kloepper, J.W.; Ooi, E.L.; Browdy, C.L.; Terhune, J.S. Identification of Bacillus strains for biological control of catfish pathogens. PLoS ONE 2012, 7, e45793. [Google Scholar] [CrossRef]
- Cai, W.; Arias, C.R. Biofilm formation on aquaculture substrates by selected bacterial fish pathogens. J. Aquat. Anim. Health 2017, 29, 95–104. [Google Scholar] [CrossRef] [PubMed]
- Cai, W.; Willmon, E.; Burgos, F.A.; Ray, C.L.; Hanson, T.; Arias, C.R. Biofilm and Sediment are Major Reservoirs of Virulent Aeromonas hydrophila (vAh) in Catfish Production Ponds. J. Aquat. Anim. Health 2019, 31, 112–120. [Google Scholar] [CrossRef]
- Akgul, A.; Lawrence, M.L.; Karsi, A. Stress-related genes promote Edwardsiella ictaluri pathogenesis. PLoS ONE 2018, 13, e0194669. [Google Scholar] [CrossRef]
- Waltman, W.D.; Shotts, E.B.; Hsu, T.C. Biochemical characteristics of Edwardsiella ictaluri. Appl. Environ. Microbiol. 1986, 51, 101–104. [Google Scholar] [CrossRef] [PubMed]
- Griffin, M.J.; Reichley, S.R.; Greenway, T.E.; Quiniou, S.M.; Ware, C.; Gao, D.X.; Gaunt, P.S.; Yanong, R.P.E.; Pouder, D.B.; Soto, E. Comparison of Edwardsiella ictaluri isolates from different hosts and geographic origins. J. Fish Dis. 2016, 39, 947–969. [Google Scholar] [CrossRef] [PubMed]
- Machimbirike, V.I.; Crumlish, M.; Dong, H.T.; Santander, J.; Khunrae, P.; Rattanarojpong, T. Edwardsiella ictaluri: A systemic review and future perspectives on disease management. Rev. Aquac. 2022, 14, 1613–1636. [Google Scholar] [CrossRef]
- Plumb, J.A.; Quinlan, E.E. Survival of Edwardsiella ictaluri in pond water and bottom mud. Prog. Fish Cult. 1986, 48, 212–214. [Google Scholar] [CrossRef]
- Davis, H.S. A new bacterial disease of freshwater fishes. Bull. U. S. Bur. Fish. 1922, 38, 261–280. [Google Scholar]
- Ordal, E.J.; Rucker, R.R. Pathogenic myxobacteria. Exp. Biol. Med. 1944, 56, 15–18. [Google Scholar] [CrossRef]
- Garnjobst, L. Cytophaga columnaris (Davis) in pure culture: A myxobacterium pathogenic to fish. J. Bacteriol. 1945, 49, 113–128. [Google Scholar] [CrossRef]
- Bernardet, J.F.; Grimont, P.A. Deoxyribonucleic acid relatedness and phenotypic characterization of Flexibacter columnaris sp. nov., nom. rev., Flexibacter psychrophilus sp. nov., nom. rev., and Flexibacter maritimus Wakabayashi, Hikida, and Masumura 1986. Int. J. Syst. Evol. Microbiol. 1989, 39, 346–354. [Google Scholar] [CrossRef]
- Bernardet, J.F.; Segers, P.; Vancanneyt, M.; Berthe, F.; Kersters, K.; Vandamme, P. Cutting a Gordian knot: Emended classification and description of the genus Flavobacterium, emended description of the family Flavobacteriaceae, and proposal of Flavobacterium hydatis nom. nov.(basonym, Cytophaga aquatilis Strohl and Tait 1978). Int. J. Syst. Evol. Microbiol. 1996, 46, 128–148. [Google Scholar] [CrossRef]
- LaFrentz, B.R.; Waldbieser, G.C.; Welch, T.J.; Shoemaker, C.A. Intragenomic heterogeneity in the 16S rRNA genes of Flavobacterium columnare and standard protocol for genomovar assignment. J. Fish Dis. 2014, 37, 657–669. [Google Scholar] [CrossRef]
- Tekedar, H.C.; Karsi, A.; Reddy, J.S.; Nho, S.W.; Kalindamar, S.; Lawrence, M.L. Comparative genomics and transcriptional analysis of Flavobacterium columnare strain ATCC 49512. Front. Microbiol. 2017, 8, 588. [Google Scholar] [CrossRef]
- LaFrentz, B.R.; García, J.C.; Waldbieser, G.C.; Evenhuis, J.P.; Loch, T.P.; Liles, M.R.; Wong, F.S.; Chang, S.F. Identification of four distinct phylogenetic groups in Flavobacterium columnare with fish host associations. Front. Microbiol. 2018, 9, 452. [Google Scholar] [CrossRef] [PubMed]
- Cai, W.; De La Fuente, L.; Arias, C.R. Biofilm formation by the fish pathogen Flavobacterium columnare: Development and parameters affecting surface attachment. Appl. Environ. Microbiol. 2013, 79, 5633–5642. [Google Scholar] [CrossRef] [PubMed]
- Waśkiewicz, A.; Irzykowska, L. Flavobacterium spp. Characteristics, Occurrence, and Toxicity. In Encyclopedia of Food Microbiology, 2nd ed.; Batt, C.A., Patel, P., Tortorello, M.L., Eds.; Academic Press: Cambridge, MA, USA; pp. 938–942. ISBN 9780123847331.
- Beck, B.H.; Barnett, L.M.; Farmer, B.D.; Peatman, E.; Carter, D. Kaolinitic clay protects against Flavobacterium columnare infection in channel catfish Ictalurus punctatus (Rafinesque). J. Fish Dis. 2015, 38, 241–248. [Google Scholar] [CrossRef]
- García, J.C.; LaFrentz, B.R.; Waldbieser, G.C.; Wong, F.S.; Chang, S.F. Characterization of atypical Flavobacterium columnare and identification of a new genomovar. J. Fish Dis. 2018, 41, 1159–1164. [Google Scholar] [CrossRef]
- Welker, T.L.; Shoemaker, C.A.; Arias, C.R.; Klesius, P.H. Transmission and detection of Flavobacterium columnare in channel catfish Ictalurus punctatus. Dis. Aquat. Org. 2005, 63, 129–138. [Google Scholar] [CrossRef]
- Thune, R.L.; Stanley, L.A.; Cooper, R.K. Pathogenesis of gram-negative bacterial infections in warmwater fish. Annu. Rev. Fish Dis. 1993, 3, 37–68. [Google Scholar] [CrossRef]
- Declercq, A.M.; Haesebrouck, F.; Van den Broeck, W.; Bossier, P.; Decostere, A. Columnaris disease in fish: A review with emphasis on bacterium-host interactions. Vet. Res. 2013, 44, 27. [Google Scholar] [CrossRef]
- Klesius, P.H.; Shoemaker, C.A.; Evans, J.J. Flavobacterium columnare chemotaxis to channel catfish mucus. FEMS Microbiol. Let. 2008, 288, 216–220. [Google Scholar] [CrossRef]
- Zhou, T.; Yuan, Z.; Tan, S.; Jin, Y.; Yang, Y.; Shi, H.; Wang, W.; Niu, D.; Gao, L.; Jiang, W.; et al. A review of molecular responses of catfish to bacterial diseases and abiotic stresses. Front. Physiol. 2018, 9, 1113. [Google Scholar] [CrossRef]
- Shoemaker, C.A.; Klesius, P.H.; Drennan, J.D.; Evans, J.J. Efficacy of a modified live Flavobacterium columnare vaccine in fish. Fish Shellfish Immunol. 2011, 30, 304–308. [Google Scholar] [CrossRef]
- LaFrentz, B.R.; Goodwin, A.E.; Shoemaker, C.A. 1.2.3 Columnaris disease. In FHS Blue Book: Diagnostic Procedures for Finfish and Shellfish Pathogens; AFS-FHS (American Fisheries Society-Fish Health Section): Bethesda, MD, USA, 2014. [Google Scholar]
- Decostere, A.; Haesebrouck, F.; Devriese, L.A. Characterization of four Flavobacterium columnare (Flexibacter columnaris) strains isolated from tropical fish. Vet. Microbiol. 1998, 62, 35–45. [Google Scholar] [CrossRef] [PubMed]
- Farmer, B.D. Improved Methods for the Isolation and Characterization of Flavobacterium columnare. Master’s Thesis, Louisiana State University and Agricultural & Mechanical College, Baton Rouge, LA, USA, 2004. [Google Scholar]
- Shoemaker, C.A.; LaFrentz, B.R. Growth and survival of the fish pathogenic bacterium, Flavobacterium columnare, in tilapia mucus and porcine gastric mucin. FEMS Microbiol. Let. 2015, 362, 1–5. [Google Scholar] [CrossRef]
- Loch, T.P.; Faisal, M. Emerging flavobacterial infections in fish: A review. J. Adv. Res. 2015, 6, 283–300. [Google Scholar] [CrossRef]
- Humphry, D.R.; George, A.; Black, G.W.; Cummings, S.P. Flavobacterium frigidarium sp. nov., an aerobic, psychrophilic, xylanolytic and laminarinolytic bacterium from Antarctica. Int. J. Syst. Evol. Microbiol. 2001, 51, 1235–1243. [Google Scholar] [CrossRef] [PubMed]
- Wang, Z.W.; Liu, Y.H.; Dai, X.; Wang, B.J.; Jiang, C.Y.; Liu, S.J. Flavobacterium saliperosum sp. nov., isolated from freshwater lake sediment. Int. J Syst. Evol. Microbiol. 2006, 56, 439–442. [Google Scholar] [CrossRef]
- Kayansamruaj, P.; Dong, H.T.; Hirono, I.; Kondo, H.; Senapin, S.; Rodkhum, C. Comparative genome analysis of fish pathogen Flavobacterium columnare reveals extensive sequence diversity within the species. Infect. Genet. Evol. 2017, 54, 7–17. [Google Scholar] [CrossRef] [PubMed]
- Arias, C.R.; LaFrentz, S.; Cai, W.; Olivares-Fuster, O. Adaptive response to starvation in the fish pathogen Flavobacterium columnare: Cell viability and ultrastructural changes. BMC Microbiol. 2012, 12, 266. [Google Scholar] [CrossRef]
- Cai, W.; De La Fuente, L.; Arias, C.R. Transcriptome analysis of the fish pathogen Flavobacterium columnare in biofilm suggests calcium role in pathogenesis. BMC Microbiol. 2019, 19, 151. [Google Scholar] [CrossRef]
- Steeby, J.A.; Hargreaves, J.A.; Tucker, C.S.; Kingsbury, S. Accumulation, organic carbon and dry matter concentration of sediment in commercial channel catfish ponds. Aquac. Eng. 2004, 30, 115–126. [Google Scholar] [CrossRef]
- Boyd, C.E.; Queiroz, J.; Lee, J.; Rowan, M.; Whitis, G.N.; Gross, A. Environmental Assessment of Channel Catfish Ictalurus punctatus Farming in Alabama. J. World Aquac. Soc. 2000, 31, 511–544. [Google Scholar] [CrossRef]
- Tuttle, J.T.; Bruce, T.J.; Abdelrahman, H.A.; Roy, L.A.; Butts, I.A.E.; Beck, B.H.; Kelly, A.M. Persistence of a Wild-Type Virulent Aeromonas hydrophila Isolate in Pond Sediments from Commercial Catfish Ponds: A Laboratory Study. Vet. Sci. 2023, 10, 236. [Google Scholar] [CrossRef] [PubMed]
- Nucleotide. Bethesda (MD): National Library of Medicine (US), National Center for Biotechnology Information; (1988)—Accession No. JX 866969.1, Edwardsiella ictaluri Strain S97-773 16S Ribosomal RNA Gene, Partial Sequence. Available online: https://www.ncbi.nlm.nih.gov/nuccore/JX866969.1 (accessed on 18 February 2023).
- Zhang, Y.; Arias, C.R.; Shoemaker, C.A.; Klesius, P.H. Comparison of lipopolysaccharide and protein profiles between Flavobacterium columnare strains from different genomovars. J. Fish Dis. 2006, 29, 657–663. [Google Scholar] [CrossRef]
- Nucleotide. Bethesda (MD): National Library of Medicine (US), National Center for Biotechnology Information; [1988]—Accession No. MG 516971, Flavobacterium covae Strain ALG-00-530 16S Ribosomal RNA Gene, Partial Sequence. Available online: https://www.ncbi.nlm.nih.gov/nuccore/MG516971 (accessed on 18 February 2023).
- Decostere, A.; Haesebrouck, F.; Devriese, L.A. Shieh medium supplemented with tobramycin for selective isolation of Flavobacterium columnare (Flexibacter columnaris) from diseased fish. J. Clin. Microbiol. 1997, 35, 322–324. [Google Scholar] [CrossRef] [PubMed]
- Wise, A.L.; LaFrentz, B.R.; Kelly, A.M.; Liles, M.R.; Griffin, M.J.; Beck, B.H.; Bruce, T.J. The Infection Dynamics of Experimental Edwardsiella ictaluri and Flavobacterium covae Coinfection in Channel Catfish (Ictalurus punctatus). Pathogens 2023, 12, 462. [Google Scholar] [CrossRef]
- Chen, C.Y.; Nace, G.W.; Irwin, P.L. A 6 × 6 drop plate method for simultaneous colony counting and MPN enumeration of Campylobacter jejuni, Listeria monocytogenes, and Escherichia coli. J. Microbiol. Methods 2003, 55, 475–479. [Google Scholar] [CrossRef] [PubMed]
- Shotts, E.B., Jr.; Waltman, W.D., II. A medium for the selective isolation of Edwardsiella ictaluri. J. Wildl. Dis. 1990, 26, 214–218. [Google Scholar] [CrossRef]
- Buck, J.D.; Cleverdon, R.C. The spread plate as a method for the enumeration of marine bacteria 1, 2. Limnol. Oceanogr. 1960, 5, 78–80. [Google Scholar] [CrossRef]
- Griffin, M.J.; Mauel, M.J.; Greenway, T.E.; Khoo, L.H.; Wise, D.J. A real-time polymerase chain reaction assay for quantification of Edwardsiella ictaluri in catfish pond water and genetic homogeneity of diagnostic case isolates from Mississippi. J. Aqut. Anim. Health 2011, 23, 178–188. [Google Scholar] [CrossRef]
- Panangala, V.S.; Shoemaker, C.A.; Klesius, P.H. TaqMan real-time polymerase chain reaction assay for rapid detection of Flavobacterium columnare. Aquac. Res. 2007, 38, 508–517. [Google Scholar] [CrossRef]
- Marchesi, J.R.; Sato, T.; Weightman, A.J.; Martin, T.A.; Fry, J.C.; Hiom, S.J.; Wade, W.G. Design and evaluation of useful bacterium-specific PCR primers that amplify genes coding for bacterial 16S rRNA. Appl. Environ. Microbiol. 1998, 64, 795–799. [Google Scholar] [CrossRef]
- Tamura, K.; Stecher, G.; Kumar, S. MEGA11: Molecular evolutionary genetics analysis version 11. Mol. Biol. Evol. 2021, 38, 3022–3027. [Google Scholar] [CrossRef] [PubMed]
- Altschul, S.F.; Gish, W.; Miller, W.; Myers, E.W.; Lipman, D.J. Basic local alignment search tool. J. Mol. Biol. 1990, 215, 403–410. [Google Scholar] [CrossRef] [PubMed]
- Benjamini, Y.; Hochberg, Y. Controlling the false discovery rate: A practical and powerful approach to multiple testing. J. R. Stat. Soc. Ser. B 1995, 57, 289–300. [Google Scholar] [CrossRef]
- Hussain, A.S.; Fogelman, K.; Abdelrahman, H.A.; Roy, L.A.; Stoeckel, J. Relationship between aerobic scope and upper thermal limits of pacific white shrimp (Litopenaeus vannamei) in low-salinity culture systems. Aquaculture 2023, 569, 739402. [Google Scholar] [CrossRef]
- Berry, L.N.; Helwig, N.E. Cross-validation, information theory, or maximum likelihood? A comparison of tuning methods for penalized splines. Stats 2021, 4, 701–724. [Google Scholar] [CrossRef]
- Efron, B.; Tibshirani, R. An Introduction to the Bootstrap, Monographs on Statistics and Applied Probability, 1st ed.; Chapman & Hall; CRC: New York, NY, USA, 1993; ISBN 9780412042317. [Google Scholar]
- Canty, A.; Ripley, B. Boot: Bootstrap R (S-Plus) Functions, R Package, Version 1.3–28; R Core Team: Vienna, Austria, 2021. [Google Scholar]
- Faul, F.; Erdfelder, E.; Lang, A.-G.; Buchner, A. G* Power 3: A flexible statistical power analysis program for the social, behavioral, and biomedical sciences. Behav. Res. Methods 2007, 39, 175–191. [Google Scholar] [CrossRef]
- R Core Team. R: A Language and Environment for Statistical Computing. Available online: https://www.R-project.org/ (accessed on 12 September 2022).
- SAS. The SAS System for Windows; Release 9.4; SAS Institute Inc.: Cary, NC, USA, 2013. [Google Scholar]
- Hassan, E.S.; Mahmoud, M.M.; Kawato, Y.; Nagai, T.; Kawaguchi, O.; Iida, Y.; Yuasa, K.; Nakai, T. Subclinical Edwardsiella ictaluri infection of wild ayu Plecoglossus altivelis. Fish Pathol. 2012, 47, 64–73. [Google Scholar] [CrossRef]
- Acharya, M.; Maiti, N.K.; Mohanty, S.; Mishra, P.; Samanta, M. Genotyping of Edwardsiella tarda isolated from freshwater fish culture system. Comp. Immunol. Microbiol. Infect. Dis. 2007, 30, 33–40. [Google Scholar] [CrossRef]
- Maiti, N.K.; Mandal, A.; Mohanty, S.; Mandal, R.N. Phenotypic and genetic characterization of Edwardsiella tarda isolated from pond sediments. Comp. Immunol. Microbiol. Infect. Dis. 2009, 32, 1–8. [Google Scholar] [CrossRef]
- Ugochukwu, K.C.; Agha, N.C.; Ogbulie, J.N. Lipase activities of microbial isolates from soil contaminated with crude oil after bioremediation. Afr. J Biotechnol. 2008, 7, 2881–2884. [Google Scholar]
- Elbediwi, M.; Li, Y.; Paudyal, N.; Pan, H.; Li, X.; Xie, S.; Rajkovic, A.; Feng, Y.; Fang, W.; Rankin, S.C.; et al. Global burden of colistin-resistant bacteria: Mobilized colistin resistance genes study (1980–2018). Microorganisms 2019, 7, 461. [Google Scholar] [CrossRef] [PubMed]
- Osman, K.M.; Elhariri, M. Antibiotic resistance of Clostridium perfringens isolates from broiler chickens in Egypt. Rev. Sci. Tech. 2013, 32, 841–850. [Google Scholar] [CrossRef]
- Gogry, F.A.; Siddiqui, M.T.; Sultan, I.; Haq, Q.M.R. Current update on intrinsic and acquired colistin resistance mechanisms in bacteria. Front. Med. 2021, 8, 677720. [Google Scholar] [CrossRef] [PubMed]
- Hamel, M.; Rolain, J.M.; Baron, S.A. The history of colistin resistance mechanisms in bacteria: Progress and challenges. Microorganisms 2021, 9, 442. [Google Scholar] [CrossRef]
- Panta, P.R.; Doerrler, W.T. A link between pH homeostasis and colistin resistance in bacteria. Sci. Rep. 2021, 11, 13230. [Google Scholar] [CrossRef] [PubMed]
- Plumb, J.A.; Vinitnantharat, S. Biochemical, biophysical, and serological homogeneity of Edwardsiella ictaluri. J. Aquac. Anim. Health 1989, 1, 51–56. [Google Scholar] [CrossRef]
- Panangala, V.S.; Shoemaker, C.A.; McNulty, S.T.; Arias, C.R.; Klesius, P.H. Intra-and interspecific phenotypic characteristics of fish-pathogenic Edwardsiella ictaluri and E. tarda. Aquac. Res. 2006, 37, 49–60. [Google Scholar] [CrossRef]
- Miwa, S.; Mano, N. Infection with Edwardsiella tarda causes hypertrophy of liver cells in the Japanese flounder Paralichthys olivaceus. Dis. Aquat. Org. 2000, 42, 227–231. [Google Scholar] [CrossRef]
- Usman, H.M.; Abdulkadir, N.; Gani, M.; Maiturare, H.M. Bacterial pigments and its significance. MOJ Bioequivalence Bioavailab. 2017, 4, 00073. [Google Scholar] [CrossRef]
- Celedón, R.S.; Díaz, L.B. Natural pigments of bacterial origin and their possible biomedical applications. Microorganisms 2021, 9, 739. [Google Scholar] [CrossRef]
- Johansen, V.E.; Catón, L.; Hamidjaja, R.; Oosterink, E.; Wilts, B.D.; Rasmussen, T.S.; Sherlocka, M.M.; Inghamb, C.J.; Vignolini, S. Genetic manipulation of structural color in bacterial colonies. Proc. Natl. Acad. Sci. USA 2018, 115, 2652–2657. [Google Scholar] [CrossRef]
- Decostere, A.; Haesebrouck, F.; Turnbull, J.F.; Charlier, G. Influence of water quality and temperature on adhesion of high and low virulence Flavobacterium columnare strains to isolated gill arches. J. Fish Dis. 1999, 22, 1–11. [Google Scholar] [CrossRef]
- Straus, D.L.; Farmer, B.D.; Beck, B.H.; Bosworth, B.G.; Torrans, E.L.; Tucker, C.S. Water hardness influences Flavobacterium columnare pathogenesis in channel catfish. Aquaculture 2015, 435, 252–256. [Google Scholar] [CrossRef]
- Nguyen, T.K.M.; Tu, T.D.; Channarong, R.; Dong, T.H. Effect of sodium chloride and temperature on biofilm formation and virulence of Flavobacterium columnare isolated from striped catfish (Pangasianodon hypophthalmus). Can Tho Univ. J. Sci. 2020, 12, 66–72. [Google Scholar] [CrossRef]
- Mohamed, M.H.; Refat, N.A.A. Pathological evaluation of probiotic, Bacillus subtilis, against Flavobacterium columnare in Tilapia nilotica (Oreochromis niloticus) fish in Sharkia Governorate, Egypt. J. Am. Sci. 2011, 7, 244–256. [Google Scholar]
- Boutin, S.; Bernatchez, L.; Audet, C.; Derôme, N. Antagonistic effect of indigenous skin bacteria of brook charr (Salvelinus fontinalis) against Flavobacterium columnare and F. psychrophilum. Vet. Microbiol. 2012, 155, 355–361. [Google Scholar] [CrossRef] [PubMed]
- Schrader, K.K. Compounds with inhibitory activity against the channel catfish pathogens Edwardsiella ictaluri and Flavobacterium columnare. N. Am. J. Aquac. 2008, 70, 147–153. [Google Scholar] [CrossRef]
- Shieh, H.S. Studies on the nutrition of a fish pathogen, Flexibacter columnaris. Microbiol. Lett. 1980, 13, 129–133. [Google Scholar]
- Cain, K.D.; LaFrentz, B.R. Laboratory maintenance of Flavobacterium psychrophilum and Flavobacterium columnare. Curr. Protoc. Microbiol. 2007, 6, 13B.1.1–13B1.12. [Google Scholar] [CrossRef]
- Gao, D.X.; Gaunt, P.S. Development of new G media for culture of Flavobacterium columnare and comparison with other media. Aquaculture 2016, 463, 113–122. [Google Scholar] [CrossRef]
- Song, Y.L.; Fryer, J.L.; Rohovec, J.S. Comparison of six media for the cultivation of Flexibacter columnaris. Fish Pathol. 1988, 23, 91–94. [Google Scholar] [CrossRef]
- Tamaki, H.; Hanada, S.; Kamagata, Y.; Nakamura, K.; Nomura, N.; Nakano, K.; Matsumura, M. Flavobacterium limicola sp. nov., a psychrophilic, organic-polymer-degrading bacterium isolated from freshwater sediments. Int. J. Syst. Evol. Microbiol. 2003, 53, 519–526. [Google Scholar] [CrossRef]
- Qu, J.H.; Yuan, H.L.; Li, H.F.; Deng, C.P. Flavobacterium cauense sp. nov., isolated from sediment of a eutrophic lake. Int. J. Syst. Evol. Microbiol. 2009, 59, 2666–2669. [Google Scholar] [CrossRef] [PubMed]
- Kunttu, H.M.; Sundberg, L.R.; Pulkkinen, K.; Valtonen, E.T. Environment may be the source of Flavobacterium columnare outbreaks at fish farms. Environ. Microbiol. Rep. 2012, 4, 398–402. [Google Scholar] [CrossRef]
- Testerman, T.; Beka, L.; McClure, E.A.; Reichley, S.R.; King, S.; Welch, T.J.; Graf, J. Detecting flavobacterial fish pathogens in the environment via high-throughput community analysis. Appl. Environ. Microbiol. 2022, 88, e02092-21. [Google Scholar] [CrossRef]
- Abdelhamed, H.; Nho, S.W.; Karsi, A.; Lawrence, M.L. The role of denitrification genes in anaerobic growth and virulence of Flavobacterium columnare. J. Appl. Microbiol. 2021, 130, 1062–1074. [Google Scholar] [CrossRef]
- Barger, P.C.; Liles, M.R.; Beck, B.H.; Newton, J.C. Differential production and secretion of potentially toxigenic extracellular proteins from hypervirulent Aeromonas hydrophila under biofilm and planktonic culture. BMC Microbiol. 2021, 21, 8. [Google Scholar] [CrossRef]
- Preena, P.G.; Swaminathan, T.R.; Kumar, V.J.R.; Singh, I.S.B. Antimicrobial resistance in aquaculture: A crisis for concern. Biologia 2020, 75, 1497–1517. [Google Scholar] [CrossRef]
- Cooper, R.K.; Starliper, C.E.; Shotts, E.B., Jr.; Taylor, P.W. Comparison of plasmids isolated from Romet-30-resistant Edwardsiella ictaluri and tribrissen-resistant Escherichia coli. J. Aquat. Anim. Health 1993, 5, 9–15. [Google Scholar] [CrossRef]
- Sun, K.; Wang, H.L.; Zhang, M.; Xiao, Z.Z.; Sun, L. Genetic mechanisms of multi-antimicrobial resistance in a pathogenic Edwardsiella tarda strain. Aquaculture 2009, 289, 134–139. [Google Scholar] [CrossRef]
- Abdelhamed, H.; Tekedar, H.C.; Ozdemir, O.; Hsu, C.Y.; Arick, M.A.; Karsi, A.; Lawrence, M.L. Complete genome sequence of multidrug-resistant Edwardsiella ictaluri strain MS-17-156. Genome Announc. 2018, 6, e00477-18. [Google Scholar] [CrossRef] [PubMed]

| Curve Descriptor | Overall | Farm A | Farm B | ||||
|---|---|---|---|---|---|---|---|
| Mean ± SE | 95% C.I. | Mean ± SE | 95% C.I. | Mean ± SE | 95% C.I. | ||
| CFU g−1 | Peak CFU g−1 (× 106) | 3.63 ± 1.31 | 1.08–6.19 | 1.29 ± 1.78 | −2.20–4.78 | 2.85 ± 1.97 | −1.01–6.71 |
| Time (day) at peak CFU g−1 | 2.93 ± 0.90 | 1.17–4.69 | 0.00 ± 2.21 | −4.32–4.32 | 0.00 ± 1.63 | −3.19–3.19 | |
| Time (day) at 90% of peak CFU g−1—lower | 2.17 ± 0.72 | 0.76–3.57 | 0.00 ± 1.38 | −2.70–2.70 | 0.00 ± 1.18 | −2.32–2.32 | |
| Time (day) at 90% of Peak CFU g−1—upper | 3.68 ± 0.72 | 2.27–5.08 | 2.41 ± 2.42 | −2.33–7.15 | 1.71 ± 1.5 | −1.23–4.64 | |
| Breadth at 90% of peak CFU g−1 | 1.51 ± 0.55 | 0.44–2.58 | 2.41 ± 2.36 | −2.21–7.03 | 1.71 ± 0.96 | −0.17–3.59 | |
| Time (day) at 80% of peak CFU g−1—lower | 1.81 ± 0.64 | 0.55–3.07 | 0.00 ± 1.16 | −2.28–2.28 | 0.00 ± 0.98 | −1.93–1.93 | |
| Time (day) at 80% of peak CFU g−1—upper | 4.04 ± 0.65 | 2.76–5.32 | 4.83 ± 2.71 | −0.48–10.13 | 3.42 ± 1.39 | 0.70–6.14 | |
| Breadth at 80% of peak CFU g−1 | 2.23 ± 0.87 | 0.53–3.93 | 4.83 ± 3.08 | −1.22–10.87 | 3.42 ± 1.44 | 0.60–6.24 | |
| Time (day) at 5% of peak CFU g−1—min | 0.00 ± 0.20 | −0.39–0.39 | 0.00 ± 0.22 | −0.43–0.43 | 0.00 ± 0.20 | −0.39–0.39 | |
| Time (day) at 5% of peak CFU g−1—max | 14.00 ± 0.47 | 13.08–14.92 | 14.00 ± 0.80 | 12.43–15.57 | 14.00 ± 1.77 | 10.52–17.48 | |
| Range at 5% of peak CFU g−1 | 14.00 ± 0.51 | 13.00–15.00 | 14.00 ± 0.83 | 12.37–15.63 | 14.00 ± 1.78 | 10.51–17.49 | |
| Log10 CFU g−1 | Peak log10 CFU g−1 | 6.32 ± 0.19 | 5.95–6.68 | 5.89 ± 1.46 | 3.04–8.75 | 6.23 ± 0.32 | 5.59–6.86 |
| Time (day) at peak log10 CFU g−1 | 3.27 ± 0.68 | 1.93–4.61 | 3.77 ± 3.11 | −2.32–9.87 | 3.31 ± 2.62 | −1.81–8.44 | |
| Time (day) at 90% of peak log10 CFU g−1—lower | 1.85 ± 0.50 | 0.86–2.83 | 1.32 ± 0.97 | −0.58–3.21 | 1.20 ± 0.78 | −0.33–2.73 | |
| Time (day) at 90% of peak log10 CFU g−1—upper | 5.37 ± 3.8 | −2.08–12.81 | 14.00 ± 3.63 | 6.88–21.12 | 6.66 ± 4.12 | −1.41–14.73 | |
| Breadth at 90% of peak log10 CFU g−1 | 3.52 ± 4.03 | −4.37–11.42 | 12.68 ± 4.08 | 4.69–20.67 | 5.46 ± 4.61 | −3.58–14.50 | |
| Time (day) at 80% of peak log10 CFU g−1—lower | 0.61 ± 0.65 | −0.66–1.87 | 0.00 ± 0.92 | −1.81–1.81 | 0.00 ± 0.55 | −1.09–1.09 | |
| Time (day) at 80% of peak log10 CFU g−1—upper | 14.00 ± 0.00 | 14.00–14.00 | 14.00 ± 0.31 | 13.39–14.61 | 14.00 ± 0.89 | 12.26–15.74 | |
| Breadth at 80% of peak log10 CFU g−1 | 13.40 ± 0.65 | 12.13–14.66 | 14.00 ± 1.00 | 12.04–15.96 | 14.00 ± 1.11 | 11.83–16.17 | |
| Colony Morphology | Sampling Day(s) | Confirmation | |||
|---|---|---|---|---|---|
| Total Score a | Query Cover b | Max Ident. c | Species ID | ||
| D | 5, 7 | 1762 | 100 | 99.37 | Burkholderia contaminans |
| F | 14 | 639 | 98 | 97.62 | Uncultured bacterium |
| H | 14 | 1954 | 100 | 99.53 | Bacillus spp. |
| I | 14 | 1599 | 100 | 98.84 | Pseudomonas aeruginosa |
| C | 1−14 | 1882 | 94 | 81.48 | Clostridium hydrogeniformans |
| G | 7, 14 | 1792 | 100 | 99.59 | Stenotrophomonas pavanii |
| A | 0−14 | 1677 | 100 | 99.61 | Edwardsiella ictaluri |
| B | 5−14 | 1628 | 100 | 98.13 | Edwardsiella ictaluri |
| E | 5, 7 | 1988 | 100 | 99.27 | Edwardsiella ictaluri |
| J | 7, 14 | 1831 | 100 | 98.90 | Edwardsiella ictaluri |
| Water Quality Parameter | Overall | Farm A | Farm B | |||
|---|---|---|---|---|---|---|
| Mean ± SE | Min–Max | Mean ± SE | Min–Max | Mean ± SE | Min–Max | |
| Total alkalinity (ppm) | 116.72 ± 3.60 | 87–174 | 109.50 ± 4.30 | 87–157 | 123.94 ± 5.37 | 90–174 |
| Total hardness (ppm) | 123.78 ± 5.03 | 67–191 | 105.44 ± 4.92 | 67–138 | 142.11 ± 6.36 | 99–191 |
| pH | 7.62 ± 0.02 | 7.3–7.9 | 7.57 ± 0.03 | 7.3–7.8 | 7.67 ± 0.03 | 7.4–7.9 |
| Phosphate (ppm) | 1.28 ± 0.20 | 0.0–4.0 | 1.62 ± 0.32 | 0.0–4.0 | 0.94 ± 0.21 | 0.0–2.8 |
| Total ammonia nitrogen (ppm) | 0.60 ± 0.11 | 0.0–2.2 | 0.32 ± 0.08 | 0.0–1.3 | 0.88 ± 0.18 | 0.1–2.2 |
| Nitrite (ppm) | 0.11 ± 0.04 | 0.0–1.0 | 0.16 ± 0.08 | 0.0–1.0 | 0.06 ± 0.02 | 0.0–0.3 |
| Nitrate (ppm) | 0.15 ± 0.06 | 0.0–1.0 | 0.0 ± 0.0 | 0.0–0.0 | 0.31 ± 0.11 | 0.0–1.0 |
| Variable | ρ | p-Value | n/Farm | |
|---|---|---|---|---|
| Raw | FDR | |||
| Alkalinity (% CaCO3 Equivalence) | 0.05 | 0.6740 | 0.2800 | 2728 |
| Aluminum (ppm) | −0.04 | 0.7617 | 0.9694 | 5249 |
| Calcium (ppm) | −0.04 | 0.7317 | 0.9694 | 5249 |
| CEC (meq 100 g−1) | −0.04 | 0.7414 | 0.9694 | 5249 |
| Copper (ppm) | 0.08 | 0.5447 | 0.9694 | 1224 |
| Iron (ppm) | 0.02 | 0.8857 | 0.9694 | 19,260 |
| Magnesium (ppm) | 0.09 | 0.4627 | 0.9694 | 896 |
| Manganese (ppm) | <0.01 | 0.9730 | 0.9694 | 422,523 |
| Organic Matter (%) | 0.03 | 0.8450 | 0.9694 | 12,627 |
| pH | −0.02 | 0.9080 | 0.9694 | 36,124 |
| Phosphorus (ppm) | 0.07 | 0.6006 | 0.9694 | 1763 |
| Potassium (ppm) | 0.08 | 0.5315 | 0.9730 | 1234 |
| Sodium (ppm) | −0.13 | 0.3089 | 0.9730 | 467 |
| Zinc (ppm) | 0.10 | 0.4373 | 0.9730 | 801 |
| Colony Morphology | Sampling Day(s) (FPT Attempt) | Confirmation | Species ID | ||
|---|---|---|---|---|---|
| Total Score a | Query Cover b | Max Ident. c | |||
| A | 3–7 (1, 2) | 1783 | 100 | 99.90 | Brevibacterium sediminis |
| B | 1–5 (1, 2) | 1670 | 100 | 100.00 | Micrococcus luteus |
| C | 1–7 (1, 2) | 2021 | 100 | 99.91 | Micrococcus sp. |
| D | 3–7 (1, 2) | 1599 | 100 | 98.74 | Sphingobium yanoikuyae |
| E | 3, 5 (1) | 1916 | 99 | 97.10 | Acinetobacter schindleri |
| F | 7 (2) | 1286 | 99 | 89.88 | Uncultured Bacterium |
| G | 3–7 (1) | 1982 | 100 | 98.57 | Massilia neuiana |
| H | 3–7 (1, 2) | 1857 | 100 | 100.00 | Stutzerimonas stutzeri |
| I | 5, 7 (2) | 1988 | 100 | 99.81 | Bacillus pseudomucoides |
| J | 7 (2) | 1607 | 100 | 99.41 | Azospirillum brasilense |
| K | 7 (1,2) | 1700 | 100 | 100.00 | Achromobacter marplate |
| L | 7 (1, 2) | 1825 | 100 | 99.50 | Cytiolbacillus sp. |
| M | 7 (1, 2) | 1858 | 98 | 95.99 | Bacillus firmus |
Disclaimer/Publisher’s Note: The statements, opinions and data contained in all publications are solely those of the individual author(s) and contributor(s) and not of MDPI and/or the editor(s). MDPI and/or the editor(s) disclaim responsibility for any injury to people or property resulting from any ideas, methods, instructions or products referred to in the content. |
© 2023 by the authors. Licensee MDPI, Basel, Switzerland. This article is an open access article distributed under the terms and conditions of the Creative Commons Attribution (CC BY) license (https://creativecommons.org/licenses/by/4.0/).
Share and Cite
Tuttle, J.T.; Bruce, T.J.; Butts, I.A.E.; Roy, L.A.; Abdelrahman, H.A.; Beck, B.H.; Kelly, A.M. Investigating the Ability of Edwardsiella ictaluri and Flavobacterium covae to Persist within Commercial Catfish Pond Sediments under Laboratory Conditions. Pathogens 2023, 12, 871. https://doi.org/10.3390/pathogens12070871
Tuttle JT, Bruce TJ, Butts IAE, Roy LA, Abdelrahman HA, Beck BH, Kelly AM. Investigating the Ability of Edwardsiella ictaluri and Flavobacterium covae to Persist within Commercial Catfish Pond Sediments under Laboratory Conditions. Pathogens. 2023; 12(7):871. https://doi.org/10.3390/pathogens12070871
Chicago/Turabian StyleTuttle, James T., Timothy J. Bruce, Ian A. E. Butts, Luke A. Roy, Hisham A. Abdelrahman, Benjamin H. Beck, and Anita M. Kelly. 2023. "Investigating the Ability of Edwardsiella ictaluri and Flavobacterium covae to Persist within Commercial Catfish Pond Sediments under Laboratory Conditions" Pathogens 12, no. 7: 871. https://doi.org/10.3390/pathogens12070871
APA StyleTuttle, J. T., Bruce, T. J., Butts, I. A. E., Roy, L. A., Abdelrahman, H. A., Beck, B. H., & Kelly, A. M. (2023). Investigating the Ability of Edwardsiella ictaluri and Flavobacterium covae to Persist within Commercial Catfish Pond Sediments under Laboratory Conditions. Pathogens, 12(7), 871. https://doi.org/10.3390/pathogens12070871

